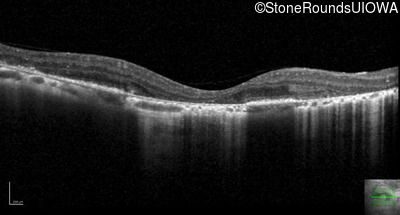
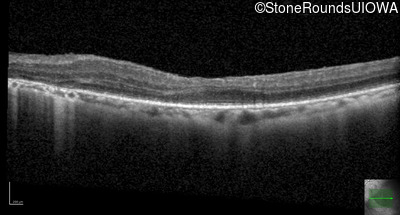
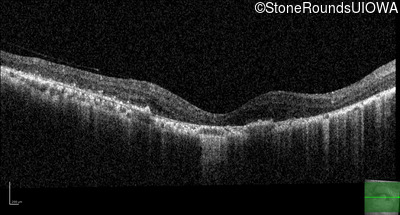
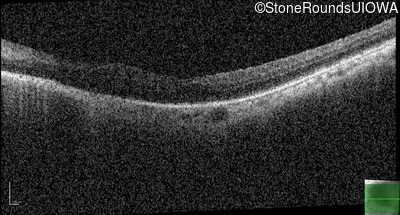

Case
SR3051
Student Mode
Alagille Syndrome (IB)
Female
Female
Hidden
SR3051
Student Mode
Alagille Syndrome (IB)
Female
Female
Highlighted Images
| Age at visit: 30 years | OD | OS |
|---|---|
History
This 30 year old woman has had poor vision in her right eye for her entire life and first noticed decreased vision in dim light and constricted fields in her left eye in middle school. She had surgery in infancy for "short gut syndrome" and had liver transplantation at age 3. She also has a history of pulmonary stenosis, scoliosis, and ataxia.
| Age at visit: 30 years |
| OD | OS | ||
|---|---|---|---|
| OD | OS | ||
|---|---|---|---|
| OD | OS | ||
|---|---|---|---|
| OD | OS | ||
|---|---|---|---|
| Age at visit: 32 years |
| OS | |||
|---|---|---|---|
| OD | OS | ||
|---|---|---|---|
Diagnosis & molecular findings
| Disease | Gene | Allele 1 variant(s) | Allele 2 variant(s) | Inheritance mode |
|---|---|---|---|---|
| Alagille Syndrome | JAG1 | Gly193del1tatG | AD |